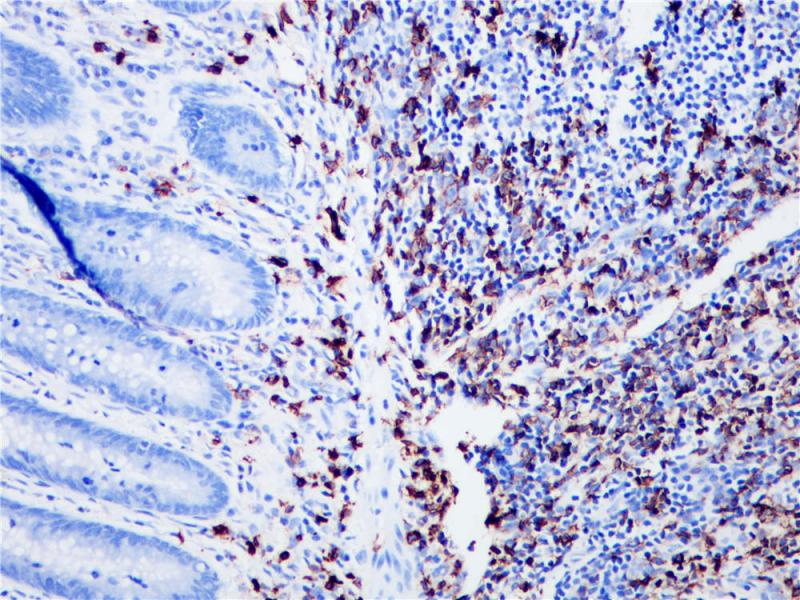
阑尾 CD20 (BP6006) 染色

产品中心

扁桃体 CD20 (BP6006) 染色
阑尾 CD20 (BP6006) 染色
CD20 重组兔单克隆抗体
CD20是一种膜内嵌的非糖基磷酸化蛋白分子,分子量约为33kDa,在B细胞活化、分化和增殖中起重要的调节作用。CD20抗原是一种B细胞分化抗原,临床应用为诊断识别B系非霍奇金淋巴瘤(NHL),还可帮助诊断结节性淋巴细胞优势型霍奇金淋巴瘤和急性淋巴细胞瘤。
Specifications
- 目录号
- BX50002
- 克隆号
- BP6006
- 阳性对照
- 扁桃体
- 亚细胞定位
- 细胞膜
- 组织类型
- FFPE
- 修复方式
- HIER
- 稀释比
- 1:100-1:200
- 规格
- 100μl/vial, 1ml/vial
- 用途
- RUO
Reference
1.N Johnson., et al. Blood 2009 113:3773-3780.
2.Clark EA., et al. Proc Natl Acad Sci U S A 1985;82:1766-1770.


